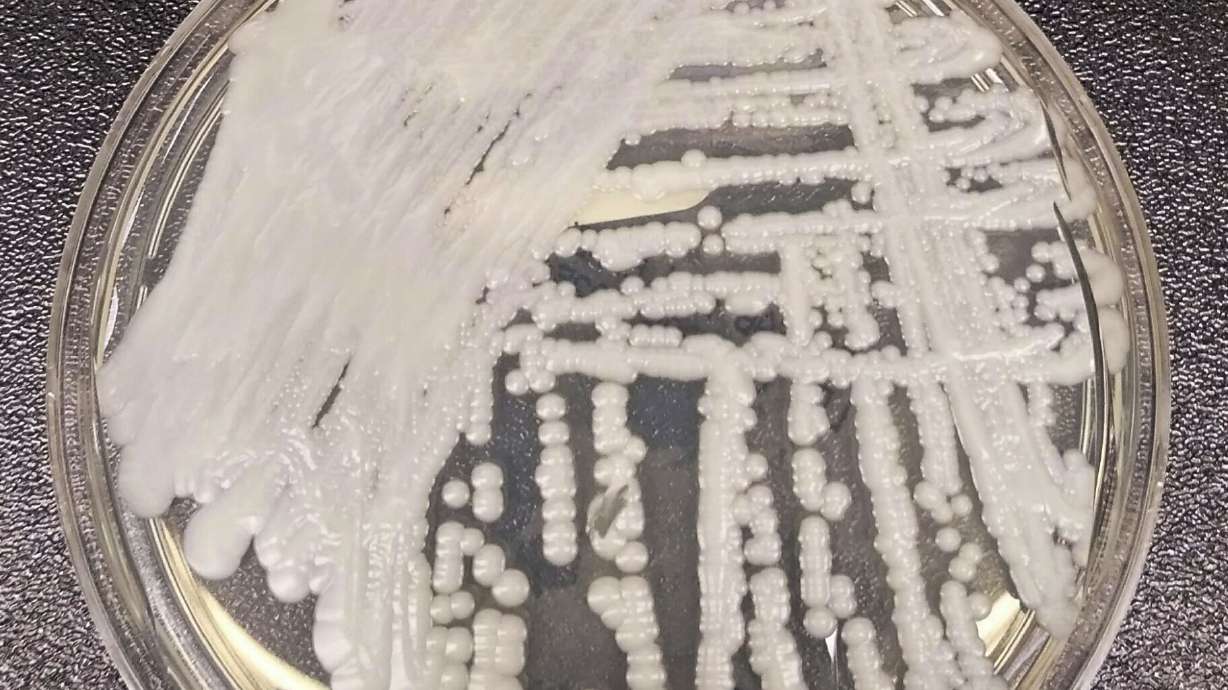
This undated photo made available by the Centers for Disease Control and Prevention shows a strain of Candida auris cultured in a petri dish at a CDC laboratory. U.S. cases of the dangerous fungus tripled over just three years.

Estimated read time: 1-2 minutes
This archived news story is available only for your personal, non-commercial use. Information in the story may be outdated or superseded by additional information. Reading or replaying the story in its archived form does not constitute a republication of the story.
NEW YORK — U.S. cases of a dangerous fungus tripled over just three years, and more than half of states have now reported it, according to a new study.
The COVID-19 pandemic likely drove part of the increase, researchers at the Centers for Disease Control and Prevention wrote in the paper published Monday by Annals of Internal Medicine. Hospital workers were strained by coronavirus patients, and that likely shifted their focus away from disinfecting some other kinds of germs, they said.
The fungus, Candida auris, is a form of yeast that is usually not harmful to healthy people but can be a deadly risk to fragile hospital and nursing home patients. It spreads easily and can infect wounds, ears and the bloodstream. Some strains are so-called superbugs that are resistant to all three classes of antibiotic drugs used to treat fungal infections.
It was first identified in Japan in 2009 and has been seen in more and more countries. The first U.S. case occurred in 2013, but it was not reported until 2016. That year, U.S. health officials reported 53 cases.
The new study founds cases have continued to shoot up, rising to 476 in 2019, to 756 in 2020, and then to 1,471 in 2021. Doctors have also detected the fungus on the skin of thousands of other patients, making them a transmission risk to others.
Many of the first U.S. cases were infections that had been imported from abroad, but now most infections are spread within the U.S., the authors noted.
The Associated Press Health and Science Department receives support from the Howard Hughes Medical Institute's Science and Educational Media Group. The AP is solely responsible for all content.